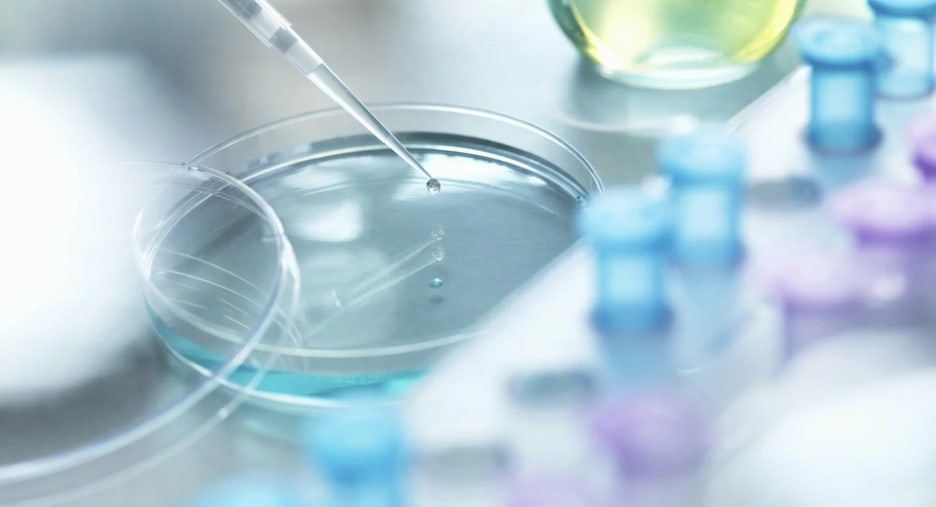

베를린에서 꼭 방문해야 할 무료 박물관들: 문화와 역사를 공짜로 만나는 방법!
베를린에는 입장료가 없는 다양한 박물관들이 있어, 역사와 문화를 무료로 즐길 수 있습니다. 다음은 그 박물관들의 목록입니다. ABC순으로 정렬되어 있습니다.
Abguss-Sammlung Antiker Plastik

베를린 자유대학교의 고대 석고 주조물 컬렉션을 소장하고 있는 박물관입니다. Abguss-Sammlung Antiker Plastik 전시회는 기원전 3천년부터 기원후 500년까지의 조각 역사를 선보이고 있습니다.
Abguss-Sammlung Antiker Plastik의 특징
- 줄리우스 시저에서 마르쿠스 아우렐리우스까지: 로마 황제들의 주조물
- 파르네세 황소 주조물
- 원반 던지기 주조물
- 현대 조각 예술의 예시들
운영시간
목요일-일요일 14:00 – 17:00

Schloßstraße 69 b, 10585 Berlin, 독일
Alliierten Museum

서방 연합국의 독일, 특히 서베를린의 정치사에 대한 박물관입니다.
전시 하이라이트
- 레이즌 폭격기 헤이스팅스 TG 503 (전 세계에 네 개만 남아 있는 표본 중 하나)
- 1940년대 프랑스 군 열차의 식당차
- 체크포인트 찰리의 첫 번째 통제실
- 1965년 CIA 기록에서 최초로 촬영된 베를린의 위성 사진
- 영국-미국 스파이 터널의 일부
운영시간
목요일-일요일 10:00 - 18:00
Startseite - AlliiertenMuseum
Herzlich willkommen auf der Webseite des AlliiertenMuseums. Hier finden Sie alle wichtigen Informationen für den Museumsbesuch.
www.alliiertenmuseum.de

Clayallee 135, 14195 Berlin, 독일
Anoha

ANOHA 어린이 세상의 하이라이트는 다음과 같습니다:
- 올라탈 수 있는 거대한 나무 방주
- 놀이를 위한 150개의 독특한 동물 조각상
- 공예, 건설 및 실험을 위한 교육 스테이션
- 작업대, 미끄럼틀 및 등반 프레임
- 워크숍 및 가이드 투어
운영 시간
화요일 - 금요일: 9:00 – 16:00
토요일, 일요일 및 공휴일: 10:00 – 17:00
ANOHA - Die Kinderwelt des Jüdischen Museums Berlin
Kommt an Bord und entdeckt ANOHA, die Kinderwelt des Jüdischen Museums Berlin. Rund um die Geschichte Arche Noahs gibt es für Kinder im Kita- und Grundschulalter viel zu entdecken, spielen und auszuprobieren.
anoha.de

Fromet-und-Moses-Mendelssohn-Platz, 10969 Berlin, 독일
Berlin Energy Museum

독일의 연간 1인당 에너지 소비량은 이제 7140kWh를 넘어서고 있습니다. 그러나 이 모든 에너지의 진정한 원동력은 무엇일까요? 발전소에서 최종 사용자에게 전기를 방해 없이 전달하려면 무엇이 필요할까요? 100년 전의 상황은 어땠을까요? 그리고 베를린의 "전기 도시"는 기술 발전에 어느 정도까지 선구적인 역할을 하고 있을까요? 베를린 에너지 박물관의 상설 전시회는 이러한 질문들에 대한 흥미로운 소개를 제공합니다. 슈테글리츠에 위치한 옛 배터리 저장소에 자리한 이 박물관은 발전의 모든 측면을 다루는 5,000여 점의 전시물을 보유하고 있습니다. 관람객이 직접 체험하고 적극적으로 참여할 수 있도록 장려하고 있습니다.
베를린 에너지 박물관의 특별 전시
- 전기 및 지역 난방을 생성하는 750kW 가스 터빈 모델
- 셀프 서비스 네트워크 스테이션 모델
- 주판에서 휴대용 계산기까지의 계산 도구
- 작동하는 튜브 메일링 시스템
- 직경 0.5미터의 하르덴베르크플라츠에서 가져온 20,000와트 램프
운영 시간
사전 등록 필요, 2-3주 전 예약 필요
Willkommen im Energie-Museum Berlin
Mitglied bei ERIH Seit 01.01.2016 sind wir Mitglied bei ERIH Die European Route of Industrial Heritage ist eine Organisation, die es sich zur Aufgabe gemacht hat, das industrielle Erbe Europas zu schützen.
www.energie-museum.de

Heizkraftwerk Steglitz, Teltowkanalstraße 9, 12247 Berlin, 독일
Charlottenburg-Wilmersdorf Museum in the Oppenheim Villa

베를린 지역의 문화와 일상 생활의 역사
샤를로텐부르크-빌머스도르프 박물관은 1987년에 설립되었습니다. 이 박물관은 지역 역사와 베를린의 문화사를 연구하고 중재하는 데 헌신하고 있습니다.
2012년 1월부터 박물관은 오펜하임 빌라에 위치해 있습니다. 이 유서 깊은 빌라는 1881년에 지어졌으며, 멘델스존과 오펜하임 가문의 여름 별장으로 여러 세대 동안 사용되었습니다.
박물관의 주요 강조점은 '서쪽!'이라는 상설 전시회로, 물건뿐만 아니라 영화와 멀티미디어로 표현된 구역의 역사에 중점을 두고 있습니다. 또한, 지역 및 문화사와 관련된 주제와 인물에 대한 특별한 임시 전시회도 열리고 있습니다. 두 번째 하이라이트는 한때 독립된 도시였던 샤를로텐부르크의 역사적 미술 컬렉션으로, 주로 19세기와 20세기 초의 그림과 조각 작품들로 구성되어 있습니다.
박물관은 성인, 청소년, 어린이 등 모든 방문객을 대상으로 다양한 프로그램을 제공하고 있습니다. 지역 및 문화사에 관한 강의, 낭독회, 기타 행사, 가이드 투어, 콘서트 등과 함께 상설 및 특별 전시회가 열리며, 오펜하임 빌라는 샤를로텐부르크 박물관 지형의 문화 중심지로 자리 잡고 있습니다.
상설 전시회에는 영어로 된 오디오 가이드와 영화도 제공됩니다. 또한, 영어 또는 프랑스어로 가이드 투어를 예약할 수 있습니다. 방문 후에는 아름다운 정원 카페에서 휴식을 취하는 것도 잊지 마세요.
운영 시간
- 화요일: 10:00 – 17:00
- 수요일: 10:00 – 17:00
- 목요일: 10:00 – 17:00
- 금요일: 10:00 – 17:00
- 토요일: 11:00 – 17:00
- 일요일: 11:00 – 17:00

Schloßstraße 55, 14059 Berlin, 독일
Deutscher Dom

역사가 깃든 장소: 도이처 돔은 젠다르멘마르크트의 아름다움을 더합니다. 내부의 전시회는 꼭 방문해볼 만한 가치가 있습니다.
미테에 위치한 젠다르멘마르크트는 두 개의 웅장한 돔 건물이 있는 인상적인 광장입니다. 이 두 건물은 프랑츠조이셔 돔과 도이처 돔으로, 유명한 콘체르트하우스를 감싸고 있습니다. 프랑츠조이셔 돔과 마찬가지로 도이처 돔도 그 위에 돔 구조물이 있어 그 이름을 따왔습니다. 많은 사람들이 오해하듯이, 이는 교회가 아닙니다(독일어로 '돔'은 대성당을 의미합니다).
도이처 돔의 역사
18세기 초에 처음 지어졌을 때 도이처 돔은 실제로 교회였습니다. 이후 프리드리히 2세 치하에서 칼 폰 곤타르트는 두 교회를 웅장한 바로크 양식의 돔으로 꾸며 장식적인 목적으로만 사용했습니다.
1848년 3월 혁명 후, 혁명가들은 전사한 동료들을 도이처 돔의 계단에 놓았고, 많은 베를린 시민들이 젠다르멘마르크트에서 그들을 추모하는 예배에 참석했습니다. 이 장면은 베를린 예술가 아돌프 멘첼의 그림 '전사한 3월 혁명가들의 안치'에 묘사되었습니다.
1943년 화재로 파괴된 도이처 돔은 오랫동안 폐허로 남아 있다가 1982년부터 1996년까지 단계적으로 재건되었습니다.
운영 시간
- 10월 - 4월: 화요일 - 일요일 오전 10시 - 오후 6시
- 5월 - 9월: 화요일 - 일요일 오전 10시 - 오후 7시

Gendarmenmarkt 1-2, 10117 Berlin, 독일
Europäisches Haus am Brandenburger Tor

브란덴부르크 문에서 몇 걸음 떨어진 곳에 위치한 유럽 하우스는 유럽과 유럽 연합에 대한 가상 여행을 제공합니다.
전시회에서는 인터랙티브 미디어 스테이션을 통해 유럽의 구성 요소, 유럽 정치의 작동 방식 및 시민들이 직접 참여할 수 있는 방법에 대해 알려줍니다.
미디어 테이블의 정보는 유럽 연합의 24개 공식 언어로 제공됩니다. 전시회의 특별한 하이라이트는 360° 영화관으로, 12분 동안 진행되는 영화에서 유럽 의회의 본회의를 체험할 수 있으며, 8분 동안 진행되는 또 다른 영화에서는 유럽이 직면한 도전 과제들을 보여줍니다. 두 영화 모두 독일어로 상영되며, 헤드폰을 통해 23개의 다른 언어로도 감상할 수 있습니다.
운영 시간
- 매일: 오전 10시 - 오후 6시

Unter den Linden 78, 10117 Berlin, 독일
Futurium - a house of futures

우리는 미래에 어떻게 살고 싶을까요? 퓨처리움은 방문객들이 다양한 미래의 관점과 가능성을 탐구하도록 자극합니다. 다양한 시나리오, 전시, 미래 실험실 및 대화와 토론을 위한 포럼이 방문객들에게 자신만의 견해를 개발하도록 초대합니다.
수도 중심에 위치한 퓨처리움은 생동감 넘치는 시나리오를 담은 전시회, 인터랙티브 체험형 실험실, 대화의 장인 이벤트 포럼을 한 지붕 아래에 모았습니다. 이곳은 흥미로운 토론, 논쟁, 탐구, 창의적인 워크숍 및 비전적인 아이디어를 위한 공간을 제공합니다. 발견하고, 논의하고, 시도해보세요 – 퓨처리움은 방문객들에게 내일의 세계를 엿볼 수 있는 기회를 제공합니다. 퓨처리움은 미래의 도전 과제와 미래를 형성할 수 있는 다양한 구성 요소들을 소개합니다. 또한, 퓨처리움은 만남의 장소이기도 합니다. 정치, 과학, 비즈니스 및 사회가 이곳에서 미래에 대한 아이디어를 교환합니다. 이러한 모든 것이 3층에 걸쳐 3,200제곱미터의 공간에서 제공됩니다.
운영 시간
- 월요일: 오전 10시 – 오후 6시
- 화요일: 휴관
- 수요일: 오전 10시 – 오후 6시
- 목요일: 오전 10시 – 오후 8시
- 금요일: 오전 10시 – 오후 6시
- 토요일: 오전 10시 – 오후 6시
- 일요일: 오전 10시 – 오후 6시

Alexanderufer 2, 10117 Berlin, 독일
Haus am Lützowplatz (House on Lützowplatz)

베를린의 주요 문화 중심지 중 하나는 뤼초플라츠에 위치한 19세기 건물에 자리하고 있습니다. 이곳은 독일 및 국제 예술가들의 현대 미술 작품을 전시하는 장소입니다. 사진, 회화에서부터 최첨단 개념 미술에 이르기까지 다양한 예술 장르가 전시됩니다. 행사 프로그램을 보완하는 정기적인 영화 상영, 공연 및 문화, 비즈니스, 예술, 과학 분야의 국제적 인물들의 강연도 열립니다. 하지만 뤼초플라츠의 하우스는 이미 잘 알려진 예술가들만을 위한 곳이 아닙니다. 오히려 신진 예술가들과 큐레이터들에게 플랫폼을 제공하고 있습니다. 다양한 관객을 끌어들이며, 이 센터는 매년 최대 여덟 개의 서로 다른 전시회를 개최합니다.
운영 시간
- 화요일: 오전 11시 – 오후 6시
- 수요일: 오전 11시 – 오후 6시
- 목요일: 오전 11시 – 오후 6시
- 금요일: 오전 11시 – 오후 6시
- 토요일: 오전 11시 – 오후 6시
- 일요일: 오전 11시 – 오후 6시

Lützowpl. 9, 10785 Berlin, 독일
House of the Wannsee Conference
Großen Wannsee 56-58에 위치한 저택은 지구를 뒤흔든 회의가 열렸던 장소입니다. 1942년, 나치 정부와 SS의 주요 인사들이 이곳에서 이른바 '유대인 문제에 대한 최종 해결책'을 논의했습니다. 반제 회의 하우스의 전시회는 이 범죄 회의와 그 계획이 어떻게 실행되었는지에 대한 통찰을 제공합니다. 전시회는 원본 문서와 시청각 자료를 통해 유럽 유대인들에게 자행된 집단 학살의 세부 내용을 보여줍니다.
전시회에서 볼 중요한 것들
- 반제 회의의 원본 문서와 참가자들에 대한 정보
- 유대인 박해의 역사를 다룬 시청각 자료
- 유대인 게토의 기능과 그곳의 일상 생활에 대한 사진과 책
- 유대인들의 강제 이송과 학살에 대한 상세 정보
- 국가사회주의 연구를 위한 멀티미디어 센터
운영 시간
- 월요일: 오전 10시 – 오후 6시
- 화요일: 오전 10시 – 오후 6시
- 수요일: 오전 10시 – 오후 6시
- 목요일: 오전 10시 – 오후 6시
- 금요일: 오전 10시 – 오후 6시
- 토요일: 오전 10시 – 오후 6시
- 일요일: 오전 10시 – 오후 6시

Am Großen Wannsee 56-58, 14109 Berlin, 독일
Jugend Museum (Youth Museum)

아이들과 청소년들의 빌라: 유겐트 박물관에서는 어린 방문객들이 놀이를 통해 독일 문화와 세계를 배웁니다.
아름다운 쇠네베르크의 빌라에서 역사는 아이들에게 생동감 있게 다가옵니다. 이곳에서는 베를린의 역사를 재미있게 체험할 수 있습니다. 세 개의 층에 걸쳐 어린 방문객들은 시간을 여행하며 다양한 시대의 삶을 발견합니다. 또한, 여러 나라에서 뿌리를 둔 베를린 사람들의 실제 삶의 이야기를 들을 수 있습니다. 베를린의 역사와 문화는 '경이의 방'과 흥미로운 전시회 속 보물 상자에서 밝혀집니다. 워크숍과 인쇄소에서 직접 체험해보세요. 극장 컬렉션도 놀이와 탐험을 초대합니다.
쇠네베르크 빌라의 하이라이트
- 베를린의 다양한 주민들을 다룬 다문화 전시회 "빌라 글로벌"
- 두 마리 거대한 새, 빌리와 루이제와 함께하는 오디오 가이드
- 지하에 있는 기적의 상자들에는 기묘한 역사적 일상 물품들이 가득합니다
- 게임과 수공예 활동이 포함된 종합적인 방학 프로그램
- "크리에이티브 선데이" - 과거로의 여행, 이어지는 창의적인 워크숍
운영 시간
- 토요일 - 목요일: 오후 2시 - 오후 6시
- 금요일: 오전 9시 - 오후 2시

Rigaer Str. 9/10, 10247 Berlin, 독일
Kunstraum Kreuzberg/Bethanien

과거 병원이었던 베타니엔은 오늘날 크로이츠베르크에서 가장 확립된 현대 예술 스튜디오 겸 예술 공간 중 하나입니다.
베타니엔 병원은 항상 대안 문화의 중심지였으며, 70년대 초반에는 점거 운동의 중심지였습니다. 오늘날 이곳은 예술 공간 크로이츠베르크/베타니엔으로 변모하여 예술가 스튜디오와 현대 전시회를 결합한 개방형 문화 포럼으로 자리 잡고 있습니다. 크로이츠베르크의 가장 오래된 건물에서 도보 투어, 워크숍, 영화 상영도 프로그램의 일환으로 진행됩니다.
베타니엔에서 볼 수 있는 것들
- 최신 주제에 관한 변화하는 전시회
- 비디오 및 오디오 아티스트를 포함한 미디어 워크숍
- 오픈 스튜디오: 1층과 2층에 있는 예술가 스튜디오 방문
- 1848-1849년 혁명 시기의 전형적인 원래 약국 내부
- 병원의 역사적인 아치형 홀에 위치한 '3 자매' 레스토랑
운영 시간
- 일요일 - 수요일: 오전 10시 - 오후 8시
- 목요일 - 토요일: 오전 10시 - 오후 10시
Mariannenpl. 2, 10997 Berlin, 독일
Marienfelde Refugee Center Museum
마리엔펠데 임시 수용소는 동독(GDR)에서 온 난민들의 첫 도착지였습니다. 여러분에게는 기억의 장소입니다 – 바로 마리엔펠데 임시 수용소 기념관입니다.
이곳은 탈출과 억압의 이야기입니다. 오늘날 마리엔펠데 임시 수용소 기념관은 박물관이자 기념관으로서, 서독으로 향했던 수백만 동독 주민들의 이야기를 전하고 있습니다. 마리엔펠데는 당시 많은 난민들에게 황금의 서쪽으로 향하는 첫 번째 정거장이었습니다. 역사적인 장소에서 박물관은 900개 이상의 문서와 원본 유물을 전시하고 있습니다. 모험적인 탈출 시도와 이 사람들이 왜 도망칠 수밖에 없었는지에 대해 알아보세요.
마리엔펠데 임시 수용소 기념관에서 제공하는 내용
- 정기적인 특별 전시회
- 탈출 이야기: 증인들이 비디오로 전하는 그들의 경험
- 난민 센터에서 40년 이상 촬영된 사진들
- 1950년대의 재구성된 난민 주택
- 서쪽에서 동쪽으로 이주한 사람들에 대한 이야기
운영 시간
- 화요일 - 금요일: 오전 9시 - 오후 5시
- 토요일 및 일요일: 오전 11시 30분 - 오후 5시

Marienfelder Allee 66-80, 12277 Berlin, 독일
Mendelssohn-Remise

멘델스존-레미제는 베를린 미테에 위치한 유대인 멘델스존 가문을 기리는 기념관입니다. 이곳은 과거 은행이자 멘델스존 가문의 거주지로, 그들의 문화, 비즈니스, 과학에 대한 막대한 기여를 알 수 있습니다. 전시회는 나치즘 시기로 이어지는 기간 동안의 가문의 감동적인 이야기를 다룹니다. 로비에 있는 미디어 스테이션에서는 펠릭스 멘델스존 바르톨디의 음악 작품이 재생되어 멘델스존 가문의 문화적 전통을 이어가고 있습니다. 다니엘 바렌보임의 지도 아래, 콘서트, 낭독회 및 토론회가 정기적으로 열립니다.
멘델스존-레미제에서 만나볼 수 있는 것들
- 예거스트라세에 있는 멘델스존 가문의 역사에 관한 상설 전시
- 멘델스존 가문의 후원: 은행가들의 초상화와 요한 하이스의 "이스라엘 자손의 이집트 탈출"과 같은 다른 예술 작품
- 멘델스존 가문의 후손들과의 인터뷰, 펠릭스 멘델스존 바르톨디, 패니 헨젤, 아놀드 멘델스존의 음악 작품을 감상할 수 있는 미디어 스테이션
- 모세 멘델스존의 기초 반지와 루이제 헨젤의 마돈나 성소
- 과거 은행 건물의 건축 양식
Mendelssohn-Gesellschaft | Home
www.mendelssohn-remise.de

Jägerstraße 51, 10117 Berlin, 독일
Military History Museum of the Bundeswehr in Berlin (Militärhistorisches Museum der Bundeswehr)

독일 연방군 군사 역사 박물관에서 항공과 공중전의 120년 역사를 체험할 수 있습니다. 베를린-가토우 비행장에서 세계에서 가장 큰 냉전 시대의 공중전 물자 컬렉션 중 하나를 볼 수 있습니다. 여기에는 제1차 세계대전 당시의 스타파이터, VIP 헬리콥터 등이 포함됩니다.
연방군 군사 역사 박물관은 베를린 서쪽의 (구) 가토우 비행장에 위치해 있습니다. 1884년부터 현재까지 독일의 군사 항공 역사에 중점을 두고 있습니다. 이 기간 동안 비행기와 헬리콥터의 발전에 대한 통찰을 이곳에서 발견할 수 있습니다. 100대 이상의 비행 차량이 넓은 야외 전시 구역을 차지하고 있습니다. 1959년의 요격 전투기 MiG-17, 군용 트럭, 군복 및 개인 장비 등의 예시가 전시되어 있습니다.
연방군 군사 역사 박물관의 하이라이트
- 수송기 더글라스 C-47B "다코타" (1948년부터 호주 왕립 공군에서 사용)
- 패트리어트 지대공 미사일 시스템의 부트 장치
- 1910년 복엽기 파르망 III의 복제 모델
- 동독 전투기 조종사 지그문트 옌의 압력복
- 제2차 세계대전 동안 어머니가 아들에게 보낸 야전 우편 편지
운영 시간
- 화요일 - 일요일: 오전 10시 – 오후 6시
Start | MHM Berlin-Gatow
Öffentlicher Nahverkehr BVG-Bus 135, Haltestellen Kurpromenade oder Seekorso, Fußweg (ca. 10 Minuten). Für Fahrradfahrer aus Berlin empfiehlt sich die BVG-Fähre F10 von Wannsee nach Kladow.
www.mhm-gatow.de

Olbrichtpl. 2, 01099 Dresden, 독일
Mitte Museum

이 박물관은 베를린의 역사적 중심지에서 일상 생활과 이야기를 담은 스냅샷을 제공합니다. 방문객들은 베딩에 있는 가장 오래된 학교 건물(1864-66년에 지어진)에서 독일 역사에 몰입할 수 있으며, 작고 정성스럽게 디자인된 전시회를 통해 19세기 이후 베를린의 미테, 티어가르텐, 베딩 지역의 생활이 어떻게 변화했는지 발견할 수 있습니다.
상설 전시회는 이 지역이 '베를린의 심장'으로 점진적으로 발전한 과정, 19세기의 산업화, 살롱 문화, 극장과 영화관, 그리고 이곳에서 살며 연구를 수행한 유명한 과학자들에 이르기까지의 역사를 개괄적으로 보여줍니다. 약 1900년경의 일상 생활은 여러 주제별 방에서 생생하게 묘사됩니다. 19세기 말에서 20세기 초의 교실은 당시 이곳에서 학교를 다니는 것이 어땠는지에 대한 인상을 제공합니다.
운영 시간
- 월요일: 오전 10시 – 오후 6시
- 화요일: 오전 10시 – 오후 6시
- 수요일: 오전 10시 – 오후 6시
- 목요일: 오전 10시 – 오후 6시
- 금요일: 오전 10시 – 오후 6시
- 토요일: 휴관
- 일요일: 오전 10시 – 오후 6시

Pankstraße 47, 13357 Berlin, 독일
Museum Berlin-Karlshorst

칼스호스트 지역의 박물관 방문은 중요한 역사적 장소로 여러분을 안내합니다. 이곳은 1945년 5월 9일, 제3제국의 고위 관리들이 무조건 항복 서명한 장소입니다. 박물관은 제2차 세계대전과 그 결과를 양국의 관점에서 탐구합니다. 또한 1917년부터 1990년대까지 독일과 러시아 간의 관계를 조명합니다. 1,000제곱미터의 전시 공간에는 군사 물품, 선전물, 일상 물품 등이 전시되어 있어 양측 군인과 민간인의 삶을 생생하게 재현합니다.
방문 하이라이트
- 박물관 외부에 전시된 소련 T34 전차
- 양측의 일상 생활과 전선에서 사용된 물품들에 대한 전시물
- 전시 및 전후 사진을 포함한 편지 컬렉션
- 소련 선전 사진 컬렉션
- 장엄한 장교 식당
운영 시간
- 화요일: 오전 10시 – 오후 6시
- 수요일: 오전 10시 – 오후 6시
- 목요일: 오전 10시 – 오후 6시
- 금요일: 오전 10시 – 오후 6시
- 토요일: 오전 10시 – 오후 6시
- 일요일: 오전 10시 – 오후 6시

Zwieseler Str. 4, 10318 Berlin, 독일
Museum Neukölln

이 박물관은 다양한 세대와 문화 간의 아이디어 교환을 촉진하는 것을 목표로 하고 있습니다. 예술가, 미디어 디자이너, 연극 교사와 협력하여 매년 네오쾰른 지역, 그 주민들, 그리고 다양한 세대와 문화를 주제로 새로운 특별 전시회가 열립니다. 이 지역, 그 역사, 일상 생활에 대한 비판적 검토와 진지한 성찰을 통해 박물관은 항상 새로운 방식으로 스스로를 재창조하고 있으며, 수많은 이벤트로 방문객들을 끌어들이고 있습니다.
2010년 5월부터 네오쾰른 박물관은 모든 보물들과 함께 구트쇼프 브리츠라는 옛 부지에 자리 잡고 있으며, '99 x 네오쾰른'이라는 새로운 상설 전시회를 선보이고 있습니다.
운영 시간
- 월요일: 오전 10시 – 오후 6시
- 화요일: 오전 10시 – 오후 6시
- 수요일: 오전 10시 – 오후 6시
- 목요일: 오전 10시 – 오후 6시
- 금요일: 오전 10시 – 오후 6시
- 토요일: 오전 10시 – 오후 6시
- 일요일: 오전 10시 – 오후 6시
https://schloss-gutshof-britz.de/

Alt-Britz 81, 12359 Berlin, 독일
Museum of Silence (Museum der Stille)

침묵의 박물관은 베를린에서 가장 특별한 박물관 중 하나일 가능성이 큽니다. 이 박물관은 러시아 화가 니콜라이 마카로프가 영원히 분주한 베를린 미테 중심부에 조용한 오아시스로 구상했습니다. 도착하면 빌헬미니언 스타일의 집 앞에 서게 됩니다. 창문은 사생활 보호를 위해 가려져 있어 내부를 들여다볼 수 없습니다. 건물에 들어서면 흙빛 붉은 벽과 천장이 있는 방이 나타납니다. 소리를 흡수하는 카펫은 모든 소음을 삼켜버립니다. 당신은 침묵 속에서 혼자 있으며, 예술 작품과 함께합니다.
침묵의 박물관 특징
- 니콜라이 마카로프의 그리자유 기법으로 그린 그림
- 미래의 침묵 공간을 위한 건축 모델
- 명상적인 흙빛 붉은 색으로 꾸며진 방들
- 마음을 편안하게 하는 조명
- 침묵
운영 시간
- 화요일: 오후 2시 – 오후 7시
- 수요일: 오후 2시 – 오후 7시
- 목요일: 오후 2시 – 오후 7시
- 금요일: 오후 2시 – 오후 7시
- 토요일: 오후 2시 – 오후 7시
- 일요일: 오후 2시 – 오후 7시

Linienstraße 154A, 10115 Berlin, 독일
Nazi Forced Labour Documentation Centre

나치 강제 노동 문서 센터는 이곳에 수감된 사람들의 이야기를 들려줍니다. 이 센터는 과거 나치 강제 노동 수용소에 위치해 있습니다.
문서 센터는 테러의 지형 재단의 일부로, 교육 및 아카이브 사이트로도 운영됩니다. 니더쇠네바이데에 위치한 문서 센터는 과거 나치 강제 노동 수용소 부지에 있으며, 이는 베를린 지역에 한때 존재했던 3,000개 이상의 유사한 수용소 중 하나입니다. 전시 공간에 들어서면, 벽에 새겨진 글, 편지, 전기 등을 통해 수감자들의 삶에 대한 매우 개인적인 통찰을 제공받게 됩니다. 두꺼운 벽 뒤의 방공호에서는 수용소에 수감된 사람들의 일상 생활에 대해 배울 수 있는 기회가 주어집니다.
나치 강제 노동 문서 센터의 하이라이트
- 가이드 투어의 일부로 제공되는 원형 그대로의 13번 막사와 방공호
- 이탈리아 전쟁 포로들이 벽에 쓴 이름과 날짜
- 사진과 글로 전하는 수용소의 일상 생활에 관한 전시
- 루프트한자 등 대형 독일 기업들이 강제 노동 프로그램에 어떻게 참여했는지에 대한 정보
- 강제 노동 수용소로 추방될 때 사람들이 걸었던 경로를 보여주는 멀티미디어 지도
운영 시간
- 화요일: 오전 10시 – 오후 6시
- 수요일: 오전 10시 – 오후 6시
- 목요일: 오전 10시 – 오후 6시
- 금요일: 오전 10시 – 오후 6시
- 토요일: 오전 10시 – 오후 6시
- 일요일: 오전 10시 – 오후 6시

Britzer Str. 5, 12439 Berlin, 독일
Plattenbau-Museumswohnung

1970년대와 1980년대에 현대 동독 아파트에 거주하는 사람들은 최고 수준의 현대적 생활을 누립니다. WBS-70 주택은 사생활이 보장된 욕실, 온수, 중앙 난방을 갖추고 있어 부족함이 없습니다. 이러한 신축 주택으로 이사하는 것은 동독 주민들에게 매우 매력적인 일이었습니다. 플라텐바우-박물관 주택은 1986년에 건축된 3베드룸 쇼 플랫으로, 세심한 디테일이 돋보입니다.
순수한 향수: 플라텐바우-박물관 주택의 하이라이트
- 원래 설비와 비품으로 완벽하게 꾸며진 3베드룸 아파트
- RFT 라페나 컬러 텔레비전과 같은 쇼홈 럭셔리 제품
- 꽃무늬 작업 앞치마, 로트캡헨 샴페인 또는 소다 사이펀과 같은 전형적인 동독 제품
- 사진 슬라이드, 메달, 책, 식기와 같은 진품 아이템
- 관리자의 생생한 일화와 개인 투어
운영 시간
- 일요일: 오후 2시 – 오후 4시

Hellersdorfer Str. 179, 12627 Berlin, 독일
SA-Gefängnis Papestraße (SA Prison Papestraße)

SA 감옥 파페슈트라세는 나치의 초기 희생자들을 기리고, 1933년 3월부터 12월까지 이곳에 수감된 사람들의 이름에 얼굴을 부여합니다.
파페슈트라세의 SA 감옥은 나치 정권의 초기 희생자들을 기억합니다. 이곳은 잘 보존된 감방을 갖춘 독특한 기념관입니다. 두꺼운 벽 뒤에서 1933년의 사건들을 생생하게 체험할 수 있습니다. 그 당시, 나치의 준군사 조직인 Sturmabteilung(SA)은 이 막사를 강제 수용소로 사용했습니다. 1933년 3월부터 12월 사이, SA는 유대인과 정권에 반대하는 사람들을 이곳에 수감했습니다. 베를린 템펠호프-쇠네베르크 지역의 이 어두운 지하실에서, 수감자들의 고통을 실제로 느낄 수 있습니다.
꼭 봐야 할 것들
- 1933년의 잘 보존된 감방들
- 수감자와 관련된 정보와 문서가 있는 아카이브실
- Sturmabteilung(SA)의 역할에 대한 정보와 사진
- 조명 설치가 있는 기념관
- 1920년대의 원래 보일러
운영 시간
- 화요일, 수요일, 목요일, 토요일, 일요일: 오후 1시 - 오후 6시
- 월요일과 금요일: 휴관
가이드 투어:
- 매주 일요일 오후 1시 (독일어로 진행)

Werner-Voß-Damm 54A, 12101 Berlin, 독일
Schöneberg Museum

쇠네베르크 박물관은 방문객들이 자신의 주변을 새로운 시각으로 바라보고 "단서 찾기"를 하도록 권장합니다.
박물관은 정기적으로 변경되는 전시회와 시티 워크를 통해 방문객들이 지역과 그 역사를 탐구하도록 영감을 줍니다. 상설 전시회인 빌라 글로벌을 방문해보세요
운영 시간
운영 시간은 박물관 웹사이트를 참조해 주세요.
https://museen-tempelhof-schoeneberg.de/

Hauptstraße 40/42, 10827 Berlin, 독일
Schwartzsche Villa

베를린 슈테글리츠 지역에 위치한 슈바르츠셰 빌라는 풍부한 문화를 제공합니다: 전시회, 콘서트, 연극이 열리며, 공연 전후에 상쾌한 음료를 즐길 수 있는 카페와 맥주 정원도 마련되어 있습니다.
슈바르츠셰 빌라는 문화적 다양성을 목표로 하며, 현대 미술 전시회, 클래식 음악 콘서트, 어린이 연극 등 다양한 프로그램이 이 슈테글리츠의 화려한 건물에서 진행됩니다.
이 빌라는 문화재로 지정되어 있으며, 남서쪽 모퉁이에는 스낵과 넓은 맥주 정원을 제공하는 카페가 있습니다. 햇빛을 즐기고 휴식을 취하며 도시의 번잡함에서 벗어나기에 완벽한 장소입니다.
슈바르츠셰 빌라는 여러 기관과 용도를 하나의 시설로 통합하여 다양하게 사용되고 있습니다:
- 다락방: 스튜디오
- 2층: 갤러리와 스튜디오 극장
- 1층:대형 및 소형 살롱(그랜드 피아노 포함), 벽난로 방 (회의실로 사용)
- 지하: 에칭 작업실, 사진 현상실, 리허설 무대
운영 시간
일반 운영 시간
- 화요일: 오전 10시 – 오후 6시
- 수요일: 오전 10시 – 오후 6시
- 목요일: 오전 10시 – 오후 6시
- 금요일: 오전 10시 – 오후 6시
- 토요일: 오전 10시 – 오후 6시
- 일요일: 오전 10시 – 오후 6시
갤러리 운영 시간
- 화요일 - 일요일: 오전 10시 - 오후 6시
카페 운영 시간
- 4월 - 10월: 매일 오전 10시 - 자정
- 11월 - 3월: 매일 오전 10시 - 오후 11시

Grunewaldstraße 55, 12165 Berlin, 독일
Stabi Kulturwerk

1826년의 거대한 지구본, J. S. 바흐의 B단조 미사곡 원본 악보, 구텐베르크 성경과 관련된 모든 것: 이제 베를린 중심부의 스타비 컬처베르크 운터 덴 린덴에서 이와 많은 다른 보물들을 감상할 수 있습니다.
베를린의 국가도서관(Staatsbibliothek)은 스타비 컬처베르크에 여러분을 초대합니다. 다양한 컬렉션에서 선별된 약 300여 점의 귀중한 유물이 전시됩니다. 이 전시물들은 여섯 세기에 걸친 도서관 역사를 반영하는 장서, 종이 원고, 인쇄된 그래픽, 지구본 및 기타 전 세계의 표본들로 구성되어 있습니다.
놓치지 말아야 할 전시물
- Flora Japonica: 1683년 일본의 식물 이미지 컬렉션
- Qabus-nama: 1698년 오스만 제국 왕자의 거울
- 쿠르트 슈비터스, 안나 블루메: 1919년 시집
- 요한 세바스티안 바흐, B단조 미사곡: 1733년 또는 1748/49년
- Mahzor: 14세기 아슈케나즈(중앙 유럽)의 유대인 기도서
운영 시간
현재 운영 시간 (2024년 7월 1일 이전까지)
- 화요일 - 일요일: 오전 10시 – 오후 6시
- 목요일: 오전 10시 – 오후 8시
- 월요일: 휴관
2024년 7월 1일부터 변경된 운영 시간
- 수요일 - 일요일: 오전 10시 – 오후 6시
- 목요일: 오전 10시 – 오후 8시
- 월요일 및 화요일: 휴관
휴관일
- 베를린 주의 공휴일
- 12월 24일 및 31일

Unter den Linden 8, 10117 Berlin, 독일
T4 - Memorial for the "euthanasia" murder victims

T4 - 나치 안락사 프로그램 희생자 기념 및 정보 센터는 베를린 티어가르텐 가장자리에 위치해 있습니다. 이 센터는 공개된 장소에서 계획되어 나치의 범죄 행위가 명백히 드러납니다. 먼저, 함정을 상징하는 파란색 유리벽을 볼 수 있습니다. 정보 게시판은 안락사 프로그램의 끔찍한 세부 사항을 전달합니다. 정보 데스크에서는 당시의 비디오와 음성 녹음을 보여주어, 범죄의 잔인성을 생생하게 전달합니다.
요약: T4 - 나치 안락사 프로그램 희생자 기념 및 정보 센터
- 24미터 하늘색 유리벽 기념물
- T4 프로그램에 대한 텍스트 정보 패널
- 제3제국의 안락사 주제에 관한 영화 자료, 멀티미디어 선택 가능
- 전쟁 증인의 음성 자료
- 장애물 없는 접근성과 쉽게 이해할 수 있는 문서 텍스트

Tiergartenstraße 4, 10785 Berlin, 독일
Tempelhof Museum

템펠호프 박물관은 베를린 지역 박물관으로서 템펠호프와 그 다양한 구역의 역사와 특성을 모든 세대에 전달합니다.
옛 알트-마리엔도르프 마을 녹지에 위치한 옛 학교 건물에서 상설 역사 전시회가 오디오 가이드와 함께 제공되며, 방문객들이 자신만의 흔적을 찾도록 장려하고 템펠호프 생활, 이 지역의 중요성과 역사, 그리고 도시 개발의 미래 계획에 대한 흥미로운 통찰을 제공합니다.
현재 사건을 주제로 한 특별 전시회와 1층 갤러리 방에서 열리는 사진 및 예술 전시회는 이 작지만 훌륭한 박물관의 무료 프로그램을 완성합니다.
운영 시간
- 월요일 - 목요일: 오후 2시 – 오후 6시
- 금요일: 오전 9시 – 오후 2시
- 토요일 및 일요일: 오후 2시 – 오후 6시

Alt-Mariendorf 43, 12107 Berlin, 독일
The museum at the Robert Koch Institute
로베르트 코흐 연구소는 세계에서 가장 오래된 생의학 연구소 중 하나입니다. 로베르트 코흐의 뛰어난 의학 연구 업적을 기리기 위해, 프로이센 정부는 1891년 왕립 프로이센 전염병 연구소를 설립했습니다. 이 연구소는 처음부터 로베르트 코흐가 이끌었으며, 후에 그의 이름을 따서 명명되었습니다. 그는 세균학과 미생물학의 창시자 중 한 사람으로 여겨지며, 독일의 감염학 기초를 마련했습니다. 그의 연구는 탄저병과 결핵 병원균의 발견을 이끌었습니다. 1905년 그는 연구 업적으로 노벨 의학상을 수상했습니다.
1910년 코흐가 연구소의 묘소에 안장될 때, 연구소의 첫 박물관 전시회가 열렸습니다. 초기 전시회는 주로 로베르트 코흐의 생애와 업적에 초점을 맞췄습니다. 박물관을 방문할 때, 묘소도 함께 관람할 수 있습니다.
로베르트 코흐 연구소 박물관에서 볼 수 있는 것들
- 140개의 전시물과 원고: 로베르트 코흐의 현미경과 노벨상 메달을 포함
- 180제곱미터의 전시 공간
- 로베르트 코흐의 묘소
운영 시간
- 월요일: 오전 10시 – 오후 5시
- 화요일: 오전 10시 – 오후 5시
- 수요일: 오전 10시 – 오후 5시
- 목요일: 오전 10시 – 오후 5시
- 금요일: 오전 10시 – 오후 3시
- 토요일/일요일/공휴일: 휴관

Nordufer 20, 13353 Berlin, 독일
The Veterinary School’s Anatomical Theatre (Tieranatomisches Theater)

1800년대, 호기심 많은 수의학 학생들 앞에서 동물 사체가 해부되고 있습니다. 현재로 빠르게 이동해 보면, 티어아나토미슈스 극장은 여전히 동물 세계를 중심으로 전시회와 이벤트를 개최하고 있습니다. 주제는 동물 해부학에서부터 일상 생활에서 인간의 동물 사용에 이르기까지 다양하며, 동시에 이 인상적인 강당은 최신 과학을 선보이는 무대로도 활용됩니다. 훔볼트 대학교의 학생들은 자신의 연구 결과를 발표할 기회를 가지며, 박물관은 예술가, 영화 제작자 및 기관들과 협력하여 현대적인 전시회, 이벤트 및 강의를 만듭니다. 인상적인 음향 덕분에 극장에서는 콘서트와 연주회도 열립니다.
티어아나토미슈스 극장의 하이라이트
- 카를 고트하르트 랑한스의 신고전주의 건축
- 베를린에서 가장 오래된 학교
- 건축과 과학의 매혹적인 조화
- 동물 해부학에 관한 과학, 역사 및 예술 전시회
- 다른 건축적으로 중요한 건물들과 동일한 캠퍼스 내에 위치
운영 시간 및 방문 정보
- 운영 시간: 화요일 - 토요일
방문 전 확인 사항:
- 티어아나토미슈스 극장은 여전히 교육을 위해 사용되는 기관이므로 매일 방문이 가능하지 않습니다. 방문하기 전에 웹사이트를 통해 운영 일정을 확인하세요.

Campus Nord, Philippstraße 13/Haus 3, 10115 Berlin, 독일
Topography of Terror

테러가 실감나는 장소이자 기억과 역사의 경고를 담은 장소인 "테러의 지형" 전시회는 1933년부터 1945년까지 나치의 주요 박해와 테러 기관들이 위치했던 부지에 있습니다. 이곳에는 게슈타포 본부, SS의 고위 지휘부 및 보안 서비스, 그리고 1939년부터는 제국 보안 본부가 자리잡고 있었습니다.
매년 200만 명 이상의 방문객이 찾는 이곳은 독일에서 가장 자주 방문되는 박물관 및 기념 센터 중 하나입니다.
운영 시간
- 매일: 오전 10시 – 오후 8시

Niederkirchnerstraße 8, 10963 Berlin, 독일
Tränenpalast

독일 분단이 많은 베를린 사람들에게 의미했던 것은 이별의 눈물이었습니다. 그들의 개인적인 이야기는 트래넨팔라스트에서 찾아볼 수 있습니다.
동독을 떠나는 일. 프리드리히스트라세 기차역의 홀에서 체크인. 수하물 및 여권 검사. 이는 매우 합리적이고 관료적으로 들리지만, 실제로는 친구와 가족을 떠나는 것, 눈물의 작별 인사를 의미했습니다. 이것이 트래넨팔라스트라는 별명을 얻게 된 이유입니다.
베를린 장벽 건설 직후인 1962년, 동독은 프리드리히스트라세 기차역에 체크인 홀을 세웠습니다. 이곳은 동베를린에서 서베를린으로 건너가는 승객들을 위한 곳이었습니다. 유리와 철강으로 만들어진 이 파빌리온은 당시 건축 양식에 매우 잘 어울렸습니다.
S-Bahn 또는 U-Bahn을 타고 서베를린으로 가고자 하는 승객들만 트래넨팔라스트에 접근할 수 있었습니다. 경찰은 여권과 비자를 확인하고, 세관원은 수하물을 검사했으며, 최종적으로 여권이 철저히 검사된 후에야 여행이 허가되었습니다.
운영 시간
- 화요일: 오전 9시 – 오후 7시
- 수요일: 오전 9시 – 오후 7시
- 목요일: 오전 9시 – 오후 7시
- 금요일: 오전 9시 – 오후 7시
- 토요일: 오전 10시 – 오후 6시
- 일요일: 오전 10시 – 오후 6시

Reichstagufer 17, 10117 Berlin, 독일
Willy Brandt Forum

사회민주당원이자 나치 반대자였던 빌리 브란트의 다채로운 삶을 발견해보세요. 그는 베를린의 시장, 독일 총리, 노벨 평화상 수상자이자 세계적인 정치인이었습니다.
빌리 브란트 포럼의 상설 전시회에서는 서방과 공산권의 관계, 동독 시민들 사이에서의 빌리 브란트의 인기, 성 스캔들 및 동독의 스파이 귄터 기욤과 같은 빌리 브란트가 총리로 재임하던 시기의 중요한 순간들을 살펴볼 수 있습니다. 이 현대적인 박물관은 그의 직업적인 삶과 비정형적인 정치 스타일에 대한 통찰을 제공합니다. 문서, 사진, 영화 및 원본 녹음을 통해 서독의 정치 역사를 깊이 있게 탐구할 수 있습니다. 빌리 브란트의 사생활과 인격에 대해서도 알아볼 수 있습니다.
빌리 브란트 포럼의 하이라이트
- 빌리 브란트의 원본 영화 및 오디오 파일
- 전 독일 총리의 대형 초상화
- 빌리 브란트의 게슈타포 인덱스 카드
- 노벨 평화상 메달
- 1969년의 공식 정부 선언문
운영 시간
- 매일: 오전 11시 - 오후 5시 (공휴일에도 개관)
- 휴관일: 12월 24일 - 26일, 12월 31일, 1월 1일
Behrenstraße 15, 10117 Berlin, 독일
Zweiradmuseum

건축가 슈테판 클링켄베르크는 두 바퀴에 열정을 가진 사람입니다. 학생 시절, 그는 오버바움브뤼케의 특별할 것 없는 마당에 오토바이와 자전거를 쌓아 두었습니다. 이 모델들은 1920년부터 1960년 사이의 역사적인 것들로, 자전거 박물관의 이상적인 출발점이 되었습니다.
이 박물관은 또한 워크숍을 운영합니다. 클링켄베르크는 오래된 작품들을 사랑스럽게 복원할 뿐만 아니라, 고충실도의 복제품도 제작합니다.
전시회의 하이라이트
- 1927년 탱크 회로가 있는 NSU
- 1962년에 발행된 복원된 500 골드 스타 BSA
- 완전한 스테이브 사이드카
- HOREX 및 BMW의 역사적인 모델들
- 1920년대부터 1950년대까지의 오토바이 및 모페드 부품의 복제품
운영 시간
겨울 | 10월 1일 – 2월 28일:
- 월요일 - 금요일: 오전 10시 - 오후 5시
- 토요일: 휴관
여름 | 3월 1일 – 9월 31일:
- 월요일 - 금요일: 오전 10시 - 오후 6시
- 매월 첫 번째 및 두 번째 토요일: 오전 10시 - 오후 2시

Köpenicker Str. 8, 10997 Berlin, 독일
